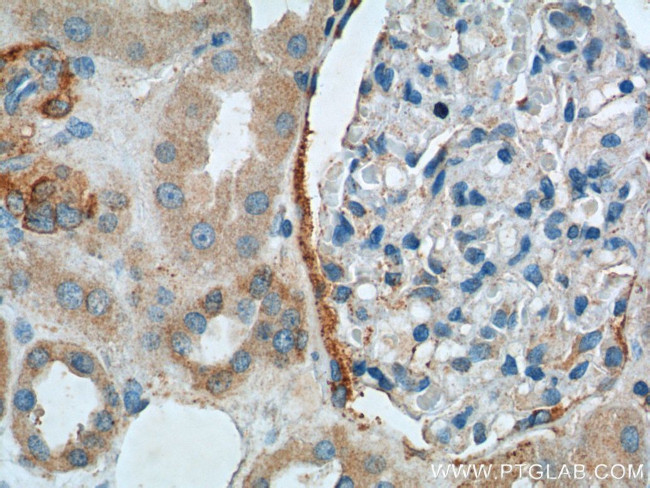
C20orf3 Antibody in Immunohistochemistry (Paraffin) (IHC (P))
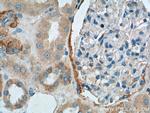
C20orf3 Antibody in Immunohistochemistry (Paraffin) (IHC (P))

Search
Proteintech
C20orf3 Polyclonal Antibody
{{$productOrderCtrl.translations['antibody.pdp.commerceCard.promotion.promotions']}}
{{$productOrderCtrl.translations['antibody.pdp.commerceCard.promotion.viewpromo']}}
{{$productOrderCtrl.translations['antibody.pdp.commerceCard.promotion.promocode']}}: {{promo.promoCode}} {{promo.promoTitle}} {{promo.promoDescription}}. {{$productOrderCtrl.translations['antibody.pdp.commerceCard.promotion.learnmore']}}
产品信息
25953-1-AP
种属反应
宿主/亚型
分类
类型
抗原
偶联物
形式
浓度
纯化类型
保存液
内含物
保存条件
运输条件
产品详细信息
Immunogen sequence: DPQPLSFKE PPLLLGVLHP NTKLRQAERL FENQLVGPES IAHIGDVMFT GTADGRVVKL ENGEIETIAR FGSGPCKTRD DEPVCGRPLG IRAGPNGTLF VADAYKGLFE VNPWKREVKL LLSSETPIEG KNMSFVNDLT VTQDGRKIYF TDSSSKWQRR DYLLLVMEGT DDGRLLEYDT VTREVKVLLD QLRFPNGVQL SPAEDFVLVA ETTMARIRRV YVSGLMKGGA DLFVENMPGF PDNIRPSSSG GYWVGMSTIR PNPGFSMLDF LSERPWIKRM IFKLFSQETV MKFVPRYSLV LELSDSGAFR RSLHDPDGLV ATYISEVHEH DGHLYLGSFR SPFLCRLSLQ AV (66-416 aa encoded by BC003501)
靶标信息
APMAP (Adipocyte Plasma Membrane Associated Protein) is a Protein Coding gene. Gene Ontology (GO) annotations related to this gene include arylesterase activity and strictosidine synthase activity. Exhibits strong arylesterase activity with beta-naphthyl acetate and phenyl acetate. May play a role in adipocyte differentiation.
仅用于科研。不用于诊断过程。未经明确授权不得转售。
生物信息学
蛋白别名: Adipocyte plasma membrane-associated protein; APMAP; C20orf3; Protein BSCv; Protein DD16
基因别名: 2310001A20Rik; AI314817; APMAP; BSCv; C20orf3; UNQ1869/PRO4305
UniProt ID: (Human) Q9HDC9, (Mouse) Q9D7N9
Entrez Gene ID: (Human) 57136, (Mouse) 71881